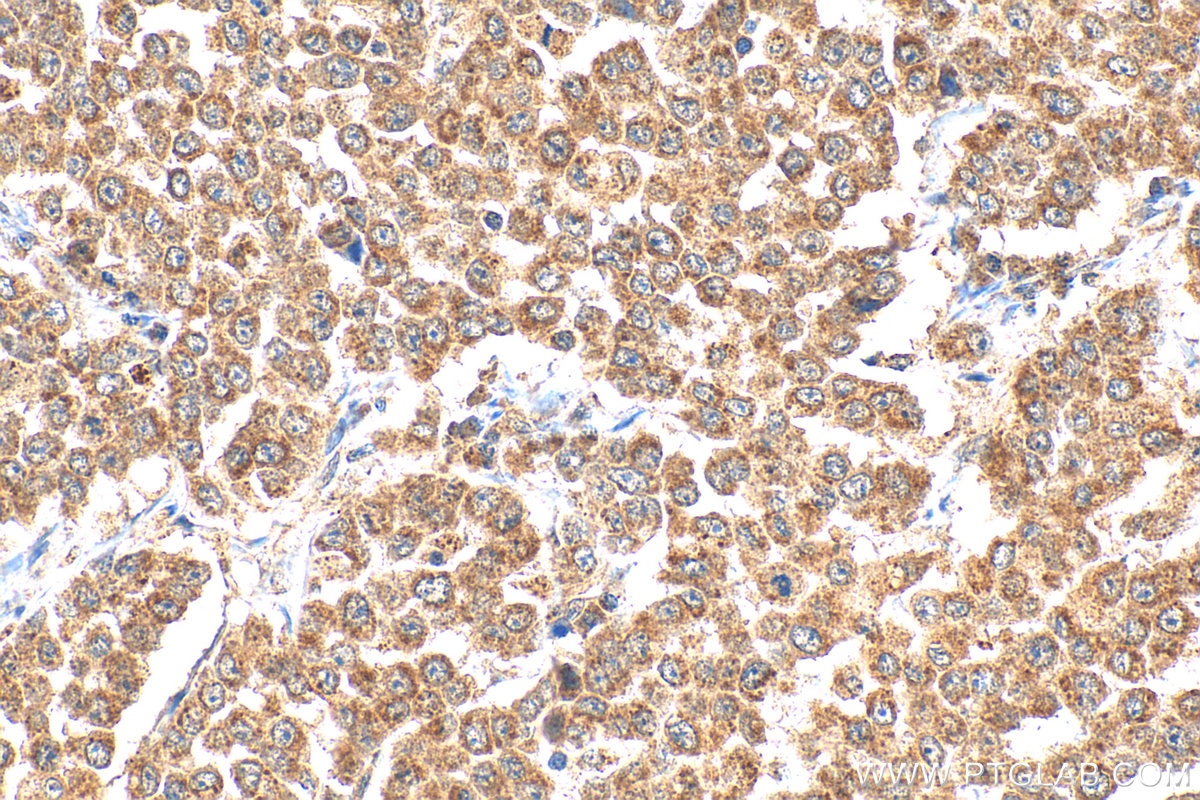
Immunohistochemistry (IHC) staining of human colon cancer tissue using GDF11 Polyclonal antibody (26715-1-AP)

Tested Applications
| Positive WB detected in | K-562 cells |
| Positive IHC detected in | human colon cancer tissue Note: suggested antigen retrieval with TE buffer pH 9.0; (*) Alternatively, antigen retrieval may be performed with citrate buffer pH 6.0 |
| Positive FC (Intra) detected in | HeLa cells |
Recommended dilution
| Application | Dilution |
|---|---|
| Western Blot (WB) | WB : 1:500-1:2000 |
| Immunohistochemistry (IHC) | IHC : 1:50-1:500 |
| Flow Cytometry (FC) (INTRA) | FC (INTRA) : 0.20 ug per 10^6 cells in a 100 µl suspension |
| It is recommended that this reagent should be titrated in each testing system to obtain optimal results. | |
| Sample-dependent, Check data in validation data gallery. | |
Published Applications
| KD/KO | See 1 publications below |
| WB | See 4 publications below |
| IHC | See 1 publications below |
Product Information
26715-1-AP targets GDF11 in WB, IHC, FC (Intra), ELISA applications and shows reactivity with human samples.
| Tested Reactivity | human |
| Cited Reactivity | human, mouse |
| Host / Isotype | Rabbit / IgG |
| Class | Polyclonal |
| Type | Antibody |
| Immunogen |
CatNo: Ag25107 Product name: Recombinant human GDF11 protein Source: e coli.-derived, PET30a Tag: 6*His Domain: 299-407 aa of NM_005811 Sequence: NLGLDCDEHSSESRCCRYPLTVDFEAFGWDWIIAPKRYKANYCSGQCEYMFMQKYPHTHLVQQANPRGSAGPCCTPTKMSPINMLYFNDKQQIIYGKIPGMVVDRCGCS Predict reactive species |
| Full Name | growth differentiation factor 11 |
| Calculated Molecular Weight | 45 kDa |
| Observed Molecular Weight | 45 kDa |
| GenBank Accession Number | NM_005811 |
| Gene Symbol | GDF11 |
| Gene ID (NCBI) | 10220 |
| RRID | AB_2918107 |
| Conjugate | Unconjugated |
| Form | Liquid |
| Purification Method | Antigen affinity purification |
| UNIPROT ID | O95390 |
| Storage Buffer | PBS with 0.02% sodium azide and 50% glycerol, pH 7.3. |
| Storage Conditions | Store at -20°C. Stable for one year after shipment. Aliquoting is unnecessary for -20oC storage. 20ul sizes contain 0.1% BSA. |
Protocols
| Product Specific Protocols | |
|---|---|
| FC protocol for GDF11 antibody 26715-1-AP | Download protocol |
| IHC protocol for GDF11 antibody 26715-1-AP | Download protocol |
| WB protocol for GDF11 antibody 26715-1-AP | Download protocol |
| Standard Protocols | |
|---|---|
| Click here to view our Standard Protocols |
Publications
| Species | Application | Title |
|---|---|---|
Placenta Follistatin dysregulation impaired trophoblast biological functions by GDF11-Smad2/3 axis in preeclampsia placentas. | ||
Int J Chron Obstruct Pulmon Dis Therapeutic Effects of Lifei Decoction in a Murine Model of COPD Induced by LPS and Cigarette Smoke | ||
Mol Neurobiol GDF11 Regulates M1 and M2 Polarization of BV2 Microglial Cells via p38 MAPK Signaling Pathway
| ||
Front Oncol Exosome-transmitted miR-3124-5p promotes cholangiocarcinoma development via targeting GDF11 | ||
J Pharm Anal Hapln1 promotes dedifferentiation and proliferation of iPSC-derived cardiomyocytes by promoting versican-based GDF11 trapping |